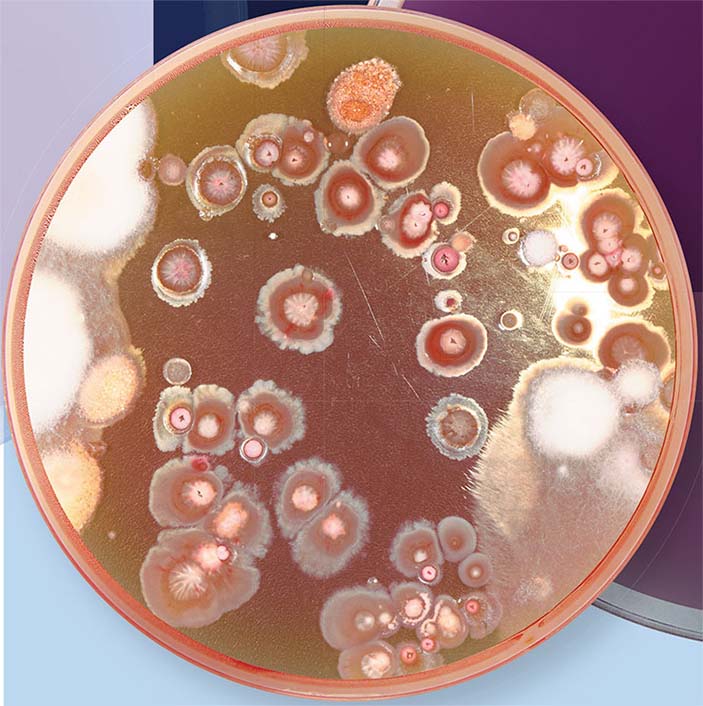
Soils for Science

Валентин Власов
«Наука из первых рук» №5/6, 2021

В последние годы в цивилизованном мире бурно развивается гражданская наука — научные исследования с привлечением широкого круга добровольцев-неспециалистов. Особенно это заметно в области биологии, где ученым приходится изучать огромное количество объектов, рассеянных на больших территориях. Десятки тысяч добровольцев участвуют в исследованиях птичьих миграций, изучении животных и растений в различных регионах обитания.
В России гражданская наука делает пока первые шаги. В сентябре 2021 г. были впервые начаты масштабные микробиологические исследования с использованием подходов гражданской науки. Но почему именно микробиология? Что может дать нам изучение микроорганизмов и причем здесь гражданская наука? На страницах журнала «НАУКА из первых рук» авторы проекта расскажут о своих планах и уже полученных результатах
Микроорганизмы, в первую очередь бактерии, — это основа биотехнологии, без них невозможно представить развитие важнейших отраслей современной промышленности. Микробы с новыми свойствами позволят решить многие проблемы сельского хозяйства, экологии, «зеленой химии»...
Так, главными инструментами генетических технологий служат высокоспецифичные ферменты, с помощью которых можно вносить целевые изменения в природные генетические программы или даже синтезировать новые. Арсенал таких ферментов уже довольно богат, но исследователи хотели бы его расширять, ведь каждый новый фермент — это новые возможности. А источники этих новых ферментов — все те же микроорганизмы.

С повышением уровня образованности населения гражданская наука становится реальной «производительной силой»: за последние два десятилетия в научных проектах по всему миру приняли участие десятки миллионов непрофессионалов (Власов, 2021). Однако российские проекты гражданской науки до сих пор либо носили игровой и образовательный характер, либо были нацелены на решение небольших конкретных задач, например на помощь в проведении археологических экспедиций.
Исследовательские микробиологические проекты Министерства науки и высшего образования РФ, стартовавшие в сентябре 2021 г., — принципиально новый, большой шаг в этом направлении. И сделан он был в рамках Федеральной научно-технической программы развития генетических технологий на 2019–2027 гг. Важность подобных технологий трудно переоценить: с их помощью сегодня создаются новые средства диагностики и терапии, сорта культурных растений и породы сельскохозяйственных животных с заданными свойствами, а также новые бактериальные штаммы, которые можно использовать в самых разных отраслях народного хозяйства.
Проекты возглавляют ведущие ученые России, а в составе участников — университеты и академические институты.
Поэтому так важно организовать масштабные исследования микробиологических объектов на территории России для поиска продуцентов ценных веществ — нам давно пора начать работать над инвентаризацией этих природных сокровищ.
Новые микробиологические проекты предполагают не только изучение природного разнообразия микроорганизмов, но и получение важных конкретных продуктов, включая, помимо уже упомянутых ферментов для нужд генетической инженерии, продуценты новых антибиотиков (бактерии и грибы), новые бактериофаги (вирусы патогенных бактерий) и даже целые консорциумы микроорганизмов, способных, к примеру, повышать урожайность растений или с пользой перерабатывать органические отходы.
Участники этих проектов хотят внести свой вклад и в решение одной из важнейших проблем современности — лекарственной устойчивости бактериальных патогенов.
Открытие первого антибиотика — одно из крупнейших научных достижений ХХ в. — произвело революцию в медицине, и создатели пенициллина в 1945 г. были удостоены Нобелевской премии. В годы Второй мировой войны производство пенициллина было налажено в Великобритании, Франции, США и Советском Союзе, и это спасло жизни миллионов людей.
В послевоенные десятилетия все крупные фармацевтические компании занялись поиском новых антибиотиков. С их появлением такие тяжелые бактериальные инфекции, как туберкулез, чума, холера, многие венерические и кишечно-желудочные болезни, перестали быть приговором. Казалось, что эти чудодейственные средства навсегда решили проблему бактериального заражения. Однако с течением времени бактерии научились противостоять патентованным препаратам, и сейчас бактериальные штаммы со множественной антибиотикоустойчивостью представляют серьезную угрозу.
Первооткрыватель антибиотиков Александр Флеминг был седьмым ребенком из восьми в семье небогатого шотландского фермера. Уже в детстве он тащил с улицы засушенных насекомых, листья, камни и прочие «экспонаты», разбрасывая их по всему дому.
В 12 лет Александр поступил в Академию Килмарнока, а спустя два года переехал в Лондон, где посещал лекции в Королевском политехническом институте. В 1901 г. он поступил на медицинские курсы в госпитале Святой Марии в Лондоне и начал весьма успешно обучаться хирургии. Позже профессор А. Райт, создавший лекарство от брюшного тифа, пригласил его в лабораторию при клинике, где занимались разработкой методов диагностики и лечения сифилиса. В 1908 г. 27‑летний Флеминг стал бакалавром бактериологии.
Во время Первой мировой войны он служил капитаном медицинской службы во Франции, где вместе с Райтом исследовал эффективность антисептиков при лечении инфицированных ран. После войны вернулся в свою лабораторию и начал работу по поиску противобактериальных средств. В 1922 г. он открыл фермент лизоцим, способный убивать бактерии и содержащийся в носовых выделениях, слюне и слезной жидкости.
Статья об открытии пенициллина вышла в 1929 г. в одном из британских журналов, посвященном экспериментальной патологии. Это сенсационное открытие состоялось, как и открытие лизоцима, на первый взгляд, случайно. В 1928 г. Флеминг, вернувшись из небольшого отпуска в лабораторию, известную своим беспорядком, обнаружил на агаре в чашке Петри, где содержались колонии стафилококков, колонию плесневых грибов рода Penicillium. Вокруг грибов питательная среда стала прозрачной из-за гибели бактериальных клеток. Так был открыт первый в мире антибиотик — «убийца бактерий».
Во время Второй мировой войны пенициллин спас десятки тысяч жизней. «Для разгрома фашизма и освобождения Франции Флеминг сделал больше, чем целые дивизии», — писали парижские газеты. Но в этом была заслуга не одного Флеминга. Сам ученый не располагал возможностями установить структуру пенициллина и организовать его наработку в больших количествах. Сделать это удалось фармакологу Г. Флори совместно с биохимиками Э. Чейном и Н. Хитли, работу которых финансировали американское и британское правительства.
В 1945 г. Флеминг, Флори и Чейн стали лауреатами Нобелевской премии в области физиологии и медицины (по правилам эта премия может быть разделена не более чем на трех человек). Сам первооткрыватель антибиотика получил 25 почетных степеней, 26 медалей, 18 премий и 13 других наград, а в 1944 г. был посвящен в рыцари.
Почему так случилось? Дело в том, что антибиотики — это средства борьбы одних микроорганизмов с другими. В результате миллиардов лет ведения этой «химический войны» бактерии не только усовершенствовали свое оружие, но и научились от него защищаться. В этом смысле устойчивость к антибиотикам — древний феномен.
Если на бактерии действовать противомикробным препаратом, они погибают. Но иногда в популяции бактерий оказываются мутанты, способные выжить в присутствии антибиотика, и они дают такое же устойчивое потомство. Подобное развитие ситуации предвидел еще создатель пенициллина Александр Флеминг, который в своей «нобелевской» лекции предупреждал об этой опасности и призывал разумно применять антибиотики. Но он не был услышан.

Справа — бактерии золотистого стафилококка (Staphylococcus aureus), устойчивые к антибиотику метициллину, которые захватывают человеческие лейкоциты. Public Domain/NIAID. Слева — колонии S. aureus на питательной среде в чашке Петри. © CC BY 2.0/VeeDunn
Золотистый стафилококк можно найти на слизистых оболочках и коже практически у каждого третьего человека на земном шаре. Он способен вызывать широкий спектр заболеваний: от кожных инфекций до тяжелых септических состояний с летальным исходом. Это одна из самых первых бактерий, у которых была обнаружена устойчивость к пенициллину: открытие было сделано в 1947 г., всего четыре года спустя после запуска лекарства в массовое производство.
Следующим антибиотиком против патогена стал метициллин, но уже в 1961 г. в Великобритании был обнаружен метициллин-резистентный штамм золотистого стафилококка (MRSA), который в 1999 г. стал причиной 37 % смертельных случаев сепсиса в этой стране.
Со временем MRSA адаптировался к выживанию в присутствии большой группы антибиотиков. Наиболее часто именно с ним связаны так называемые внутрибольничные инфекции. Сегодня в США в половине случаев всех инфекций, вызываемых золотистым стафилококком, возбудителем служат штаммы, устойчивые к пенициллину, метициллину, тетрациклину и эритромицину
Антибиотики стали применяться врачами повсеместно, и началось их массовое использование в животноводстве и птицеводстве. Как результат, люди стали потреблять антибиотики в повседневных продуктах питания, а бактерии, получая их в субтоксических концентрациях, — вырабатывать соответствующие средства защиты. Для борьбы с устойчивыми бактериями начали разрабатываться все новые антибиотики, причем каждый из них обходился все дороже, а бактерии в конце концов научились защищаться и от новых препаратов.
Благодаря такому «раскачиванию качелей» уже к 80-м гг. XX в. патогенные бактерии приспособились к основным широко применяемым антибиотикам, и сейчас встречаемость таких «супербактерий» (или мультирезистентных, т. е. устойчивых к нескольким препаратам) приблизилась к критическому уровню.
В 2017 г. ВОЗ опубликовала список из 12 видов бактерий, которые вызывают опасные заболевания (сепсис, менингит, пневмония, брюшной тиф, дизентерия и др.) и против которых антибиотики малоэффективны. Такие бактерии стали встречаться не только в больницах, но и в детских садах, фитнес-центрах, супермаркетах... К середине века ежегодные человеческие потери из-за отсутствия эффективных антибиотиков, по прогнозу ВОЗ, могут составить 10 млн человек в год.
В годы пандемии основное внимание сфокусировали на проблеме вирусных инфекций, однако в действительности бактериальные патогены не менее опасны. До начала пандемии COVID‑19 в РФ ежегодно регистрировалось около 2,5 млн случаев так называемых внутрибольничных инфекций, вызванных лекарственно-устойчивыми штаммами. Треть таких больных можно было вылечить только антибиотиками самого последнего поколения, но в некоторых случаях никакие существующие препараты не помогали.
В 2020 г. «избыточная смертность» в РФ, по официальным данным, превысила показатели предыдущего года на 17,9 %. И только треть этого прироста смертности была связана с пандемией COVID‑19. Главной причиной смертности пациентов с пневмониями оказалась суперинфекция, заражение устойчивыми к антибиотикам патогенами. В первое время после развертывания ковидных больниц случаев заражения супербактериями было немного, но через несколько месяцев в них сформировалась больничная микрофлора, устойчивая к антимикробным препаратам.
Статистика по известному Московскому клиническому центру «Коммунарка» такова: в первые трое суток после поступления больные COVID‑19 умирали от гипоксии и тромбоэмболических осложнений, но в более поздние сроки — от сепсиса, вызванного суперинфекциями. И число таких смертей составило около 73 % всех летальных исходов!
При этом точной статистики септических осложнений на всей территории России нет: в статистику летальности попадает основной диагноз пациента (например, пневмония), а сепсис, даже если он был непосредственной причиной, просто не учитывается.
На сегодняшний день в медицине применяется около 150 антибиотиков, причем некоторые из них уже малоэффективны. Доклинические испытания проходят свыше 250 препаратов, клинические — около полусотни, но пройдут годы до того момента, когда первые из них, прошедшие испытания (а это будет очень небольшая часть), поступят в больницы.
И проблема не только в этом. К середине 1990-х гг. ученые открыли все антибиотики, которые было легко найти. С тех пор не удавалось обнаружить ни одного антибиотика, принципиально отличного от известных. Только в 2015 г. при скрининге некультивируемых почвенных бактерий был открыт теиксобактин, который сейчас проходит клинические испытания.
Так в чем дело, где новые антибиотики? Неужели наука оказалась бессильна?
Конечно, люди так просто не сдались микробам, но борьба с ними оказалась тяжелой. Разработка нового антибиотика трудна, очень дорога — это сотни миллионов долларов и годы (до 10 лет!) работы — и сопровождается множеством неудач.
Кристаллографическая структура токсина синдрома токсического шока (TSST-1) золотистого стафилококка – пептида, который продуцируют до четверти всех изолятов этой бактерии. Токсин воздействует на сосудистую систему, вызывая воспаление, жар и шок. © CC BY-SA 4.0/Boghog
Первый шаг на этом пути — фундаментальные исследования: нужно найти микроорганизм, производящий антибиотик. Для этого ученым приходится исследовать тысячи образцов. Так, чтобы найти стрептомицин, было проанализировано 10 тыс. образцов бактерий, собранных на всех материках планеты. А окситетрациклин (террамицин) американской компании Pfizer появился в результате изучения 130 тыс. образцов. Кстати сказать, в ходе этой работы исследователи почти сотню раз переоткрыли стрептомицин.
После выделения в чистом виде новый антибактериальный агент должен быть испытан с точки зрения его воздействия на клетки не только бактерий, но человека. Далее кандидатный препарат проходит ряд долгих и дорогих доклинических и клинических исследований. Если он придет к «финишу», необходимо будет официально зарегистрировать его и потратить немалые средства на продвижение в клиники.
Что дальше? Новый эффективный антибиотик пускают в широкую продажу не сразу — сначала его будут применять ограниченно, в качестве резерва для тяжелых случаев. А через несколько лет повсеместного применения бактерии к нему приспособятся, и он потеряет свою высокую эффективность. Достоинства антибиотиков являются их недостатком в смысле коммерции. Работающий антибиотик вылечит инфекционное заболевание за неделю. Два десятка инъекций — и все. А где продажи? Коммерчески более привлекательны препараты, которые принимают годами, а то и всю жизнь. Так что создание антибиотиков — это рискованное вложение средств.
Ни для кого не секрет, что в современной экономической системе фармацевтические компании служат своим интересам, а не потребностям людей. Им выгодно создавать не лекарства, полностью избавляющие людей от болезни, а препараты, лишь ослабляющие болезненные симптомы. В этом смысле наиболее выгодными являются лекарства для терапии хронических заболеваний, таких как диабет, гипертония, ожирение, нарушения сна. Ведь эти препараты принимают пожизненно. Ну а самое выгодное — гомеопатические «сахарные шарики», производство которых стоит копейки, и БАДЫ, себестоимость которых — рубль.

Первый антибиотик — пенициллин — был получен из плесневого грибка рода Penicillium, случайно попавшего в чашку Петри со стафилококками. А первый производственный штамм был выделен из плесневелой дыни. Справа — мандарин, зараженный одним из пенициллов. © CC BY-SA 4.0/Ivtorov. Слева — колонии P. commune и P. chrysogenum на агаре. © CC BY-SA 4.0/Convallaria majalis
Понятно, почему многие крупные компании сторонятся этой области фармацевтики и почему в ней продолжает работать ограниченное число малых компаний.
В результате, по мнению экспертов, сейчас нет достаточного количества разработок новых антибиотиков, которые помогли бы бороться с нарастающей опасностью антибиотикорезистентных бактерий. Что будет с нами, когда перестанут работать ванкомицин и другие последние резервные антибиотики? Так что мировая проблема сегодняшнего дня — это создание менее затратных подходов к поиску и созданию антибиотиков.
Дальнейшие работы по производству новых антибиотиков невозможны без государственной поддержки и применения новых исследовательских технологий. И правительства ведущих держав мира осознают эту необходимость.
Так, в 2014 г. правительство США приняло резолюцию Combating Antibiotic Resistant Bacteria, призывающую государственные агентства и частный сектор объединить усилия для разработки новых противомикробных средств, и выделило на решение этой задачи миллиарды долларов. В США упростили правила проведения испытаний и регистрации антибиотиков, чтобы дать возможность Управлению по санитарному надзору за качеством пищевых продуктов и медикаментов (FDA) ускоренно регистрировать новые антибиотики, а пациентам с тяжелыми инфекциями — получить помощь как можно быстрее.
В 2015 г. Всемирная ассамблея здравоохранения утвердила глобальный план действий по борьбе с лекарственной устойчивостью к препаратам, включая антибиотики.

Синегнойная палочка (Pseudomonas aeruginosa) обнаруживается при абсцессах и гнойных ранах, а также при воспалениях тонкого кишечника и мочевого пузыря. Этот широко распространенный патоген отличается низкой чувствительностью к антибиотикам, в том числе благодаря формированию биопленок в виде защищенной и прикрепленной к поверхности колонии. Public Domain/CDC/Janice Haney Carr
С этого времени Национальные институты здравоохранения и Министерство здравоохранения и социальных служб США выделили миллиарды долларов на работы по изучению антибиотикорезистентности бактерий и создание новых антибиотиков с участием международных компаний. Двадцать крупных фармацевтических компаний организовали фонд AMR Action Fund — крупнейшее партнерство, инвестировавшее более 1 млрд долларов в малые компании, занимающиеся проблемой антибиотикоустойчивости. Этим компаниям оказывают техническую поддержку, им открыт доступ к ресурсам крупных компаний, таким как библиотеки химических соединений и экспертиза специалистов.
В России в 2017 г. была утверждена «Стратегия предупреждения распространения антимикробной резистентности в РФ на период до 2030 г.», и сейчас готовится соответствующая программа исследований.
В последние годы появилось осознание, что проблему поиска новых продуцентов антибиотиков можно решить за счет привлечения большого количества добровольцев, т. е. в рамках так называемой гражданской науки. Таким образом можно организовать сбор огромного количества образцов на обширных территориях, что значительно удешевит начальную стадию поиска.
Интересно, что эти современные инициативы имеют свою предысторию. Возьмем, к примеру, пенициллин, открытый Флемингом. Штамм плесени, с которым работал ученый, продуцировал лишь следовые количества антибиотика и не мог стать основой для промышленного производства. Поэтому ученые настойчиво искали более эффективные продуценты по всему миру, и в этих поисках участвовали гражданские добровольцы и даже армия. В конце концов нужный штамм был найден на заплесневевшей дыне, обнаруженной на одном из продуктовых рынков. Именно на основе этого штамма было получено большинство современных бактерий-продуцентов пенициллина.
Каждый участник австралийской программы Soils for Science может узнать, какие микробы живут в почве его земельного участка, посетив веб-галерею Института молекулярной биологии Университета Квинсленда, где опубликованы фотографии всех образцов на разных стадиях микробного роста. Фото с сайта https://imb.uq.edu.au/soilsforscience
Воодушевленные этим успехом фармацевтические компании развернули масштабные микробиологические поиски во всем мире. В 1950-х гг. такие крупные компании, как Abbott vs Merck, Pfizer, Eli Lilly и Bristol-Myers Squibb, широко использовали для этой цели подходы гражданской науки. К поискам привлекали всех: миссионеров, пилотов авиалиний, не говоря уже о самих сотрудниках компаний, их родственниках и друзьях, путешествующих по делам или для отдыха. Образцы собирали везде: в болотах, горах, на побережьях рек... В результате были получены сотни тысяч продуцентов и найдены антибиотики, использующиеся в наши дни.
Однако золотые годы «охотников за микробами» были недолгими. Находки становились все более редкими, и вскоре поиск новых штаммов стал сворачиваться. Одна из проблем — «повторные» открытия: исследователи обнаруживали в разных пробах одни и те же антимикробные вещества. Это и неудивительно, ведь в основном собирались почвенные образцы, из которых выделяли только те бактерии, которые легко культивировались в лабораторных условиях.
Большинство из того, что «лежало на поверхности», было собрано в течение нескольких лет. В 1980–1990-х гг. благодаря появлению и развитию «библиотек» органических молекул появилась надежда, что новые антибиотики можно будет создавать и без помощи бактерий-продуцентов. Однако ставка на химию не оправдалась — человек пока еще не стал таким искусным химиком, как природа.
В наши дни в ведущих странах мира реализуется несколько видов программ гражданской науки по поиску противомикробных средств. Самые простые варианты участия, ориентированные на учеников школ, предполагают сбор и отправку образцов для исследования в научные лаборатории.
К примеру, в рамках австралийской программы Soils for Science, организованной Университетом Квинсленда, всем желающим жителям Австралии бесплатно предоставляются наборы для сбора образцов. При этом организаторы просят участников по возможности поддержать проект финансово. Собранные образцы почвы направляются в университет, где микроорганизмы высеваются на питательные среды. Выделенные бактерии и грибы анализируют и помещают в криохранилище, а перспективные штаммы передаются специалистам для детальных исследований. Участники проекта могут наблюдать за ходом изучения образцов на специальном веб-сайте.

Джейд, юная участница программы Citizen Science Discovery Group Университета Оклахомы, демонстрирует пакет с образцом почвы, собранной на заднем дворе. Слева — результат культивирования микробов из этого образца, который можно увидеть, кликнув по интерактивной карте мест сбора проб. © CC BY-NC-ND 2.0/Daniel Hatton
Американский Президентский совет по науке и технологиям (PCAST) в 2012 г. сообщил, что для удовлетворения потребностей экономики страны в ближайшие годы необходимы дополнительно около 1 млн выпускников, получивших так называемое SТЕМ-образование (в области естественных наук), сверх того, что может дать система образования США в ее современном виде. Ученые рекомендовали заменить обычные образовательные программы и лабораторные курсы студентов «открытие»-ориентированными курсами, что должно было повысить мотивацию студентов к освоению естественных наук, особенно на начальной стадии обучения. Анализ показал, что к 2012 г. менее 40 % студентов, получавших образование в этой области, доходили до защиты дипломов. В качестве причины учащиеся указывали «трудные и нудные» вводные курсы, что мотивировало их переключаться на другие научные дисциплины. Сейчас около 50 % учебных университетских естественно-научных образовательных программ в США представлены программами нового типа.
Например, программа Small World Initiative® (SWI), организованная в Йельском университете в 2012 г., была направлена на вовлечение студентов в реальные исследования по поиску антибиотиков. Специалисты SWI разработали вводный курс по микробиологии, который участники программы используют для ознакомления с методами лабораторных и полевых исследований. Сейчас в этом проекте могут участвовать не только студенты, но и все желающие. В деятельность программы вовлечено множество образовательных организаций в США и 15 других странах, а ее курсы ежегодно посещают тысячи студентов и школьников.
Аналогично устроена американская краудсорсинговая программа Citizen Science Soil Collection Program, организованная в 2010 г. Университетом Оклахомы. Она нацелена на поиск почвенных грибов — продуцентов потенциальных противобактериальных, противопаразитарных и противоопухолевых препаратов. Особенность этой программы в том, что участникам предлагают собирать образцы на принадлежащих им земельных участках. Участие в программе бесплатное, но организаторы просят вносить пожертвования для покрытия расходов: 6 долларов за набор или 180 долларов для обеспечения наборами всей школы. В ходе этой программы были обнаружены продуценты полезных продуктов: например, в образце с Аляски был найден штамм, производящий соединение максимисцин с противоопухолевой активностью.
В 2015 г. стартовал масштабный британский проект Swab and Send. Желающие участвовать в нем могли приобрести за 5 фунтов (сейчас 10) пробирку, конверт с адресом и инструкции по поиску бактерий в самых загрязненных местах. В рамках этого проекта уже собрано свыше 10 тыс. образцов, из которых выделены сотни изолятов рода Bacillus, производящие вещества, убивающие патогенные бактерии, включая золотистый стафилококк и кишечную палочку со множественной лекарственной устойчивостью.

Типичный бактериофаг состоит из «головы», где содержится ДНК или РНК, окруженная белковой или липопротеиновой оболочкой, и «хвоста» — белковой трубки, которую вирус использует для «инъекции» генетического материала в бактериальную клетку. Бактериофаг размножается за счет клеточных ресурсов, а сама зараженная бактерия погибает. По: (Рябчикова, Юнусова, 2016)
Наиболее успешной «открытие»-ориентированной программой в США является SEA-PHAGES («Научно-образовательный альянс — охотники за фагами»), в рамках которой студенты занимаются поиском и изучением бактериофагов — вирусов, поражающих бактерии. Они являются перспективными «живыми антибиотиками», так как отличаются специфичностью и не представляют опасности для человеческого организма.
Программа, инициированная Университетом Питтсбурга, стала национальной и сегодня ее возглавляет Медицинский институт Говарда Хьюза — крупнейшая американская некоммерческая исследовательская организация. В программе SEA-PHAGE участвует свыше 4 тыс. студентов из более чем ста вузов из разных стран. В результате ее деятельности создана крупнейшая в мире коллекция бактериофагов, которые находят практическое применение в медицине.
Некоторые программы предусматривают более высокий уровень участия волонтеров, которым высылаются наборы для проведения экспериментов по первичному поиску бактерий, способных убивать другие бактерии. Клоны таких потенциальных продуцентов антибиотиков затем направляются в специализированные лаборатории для углубленного изучения.
Примером может служить программа Post/Biotics, реализуемая в Великобритании и США. Для первичного отбора потенциальных продуцентов противомикробных соединений его участникам предоставляется маленькая домашняя «лаборатория». Результаты тестирования образца направляются ученым. Если они представляют интерес — запрашивается образец для детальных исследований.

Из щелочно-радоновой почвы вблизи церкви Святого Сердца в г. Тонил-Норт (Бохо, Великобритания, справа) исследователи из Медицинской школы Университета Суонси выделили новый изолят стрептомицетов (Streptomyces sp. myrophorea). В экспериментах эти актинобактерии эффективно ингибировали рост нескольких супербактерий, устойчивых к антибиотикам. Предполагается, что с наличием этих бактерий связаны давно известные целебные свойств почв Бохо. Public Domain/Youngbohemian
Наконец, имеются большие программы для студентов вузов и школьников, в рамках которых их участники проходят основательное обучение микробиологии и сами проводят серьезные исследования: от сбора образцов до «расшифровки» геномов бактерий и определения структуры биологически активных веществ. Примеры — американские программы Small World Initiative (SWI) и SEA-PHAGES, организованные в соответствии с рекомендациями Президентского совета по науке и технологиям США заменить стандартные лабораторные курсы на «открытие»-ориентированные.
Где же искать продуценты новых антибиотиков? Считается, что самое лучшее место для этого — почва, где обитает и борется друг с другом с помощью химического оружия множество самых разных микроорганизмов. Именно в обычной «грязи» были найдены наиболее эффективные антибиотики.
И этот поиск можно вести буквально под ногами. Так, сотрудники Pfizer объехали весь мир, обошли горы, болота и реки, но вот парадокс: бактерия, продуцирующая окситетрациклин, была обнаружена в почве рядом с одним из заводов компании. Ванкомицин, применяемый с середины прошлого века, был найден в образце почвы, присланном миссионером из Борнео, эритромицин — в почве с Филиппин, а новый антибиотик даптомицин (кубицин) — в образце со склонов горы Арарат.

Основная часть пещерного «лунного молока» представлена достаточно плотными образованиями. Однако иногда его можно увидеть на стадии активного роста, когда отчетливо видны сплетения нитей-гиф актиномицетов (слева). Пещеры вблизи г. Кейв-Джанкшен (Орегон, США). © CC BY 2.0/Oregon Caves. Необычная форма этого наплыва «лунного молока» определяется его органическим основанием, вероятно корнем дерева, пробившимся сквозь скалу (справа). © CC BY 2.0/Oregon Caves
Геологическая изоляция пещер делает их уникальным местом как для изучения микробных адаптаций к экстремальным условиям, так и для поиска потенциальных продуцентов новых биоактивных соединений. В первую очередь речь идет о представителях актиномицетов, относящихся к роду Streptomyces, наиболее известных и широко распространенных производителях антибиотиков.
Одно из мест обитания таких бактерий — малоизученное «лунное молоко», густая желеобразная паста толщиной до 10 см, формирующаяся на пещерных поверхностях, происхождение которой остается спорным. О лечебных свойствах этой субстанции говорится уже в древних медицинских трактатах: ее применяли при лечении ран и переломов, расстройствах пищеварения и других болезнях.
Ученые из Иркутского государственного университета совместно с немецкими коллегами выделили из «лунного молока» и вод подземного озера Большой Орешной пещеры — крупнейшей карстовой пещеры Сибири — 10 новых штаммов актиномицетов, производящих множество неизвестных биологически активных веществ. Изоляты стрептомицетов продемонстрировали высокую антибактериальную и противогрибковую активность, в том числе против Candida albicans — возбудителя молочницы (Axenov-Gribanov, Voytsekhovskaya, Tokovenko et al., 2016).
Подобные результаты получили бельгийские ученые при исследовании «лунного молока» из пещеры Грот-де-Коллемболов. Им удалось выделить 78 изолятов культивируемых стрептомицетов, из которых свыше 90% подавляли жизнедеятельность широкого круга патогенных бактерий и грибков, включая Rasamsonia argillacea со множественной лекарственной устойчивостью, вызывающий микозы при муковисцидозе и хронических гранулематозных заболеваниях (Maciejewska, Adam, Martinet et al., 2016)
Бывают и более удивительные случаи. К примеру, уже более двухсот лет жители местечка Бохо в Северной Ирландии совершают паломничество в местную церковь, где похоронен приходской священник, обладавший способностью исцелять больных. Перед своей смертью в 1802 г. он сказал, что земля с его могилы будет помогать при заболеваниях, которые успешно лечил он сам. С тех пор люди берут щепотку земли с могилы, заворачивают в ткань, кладут под подушку и молятся, а после выздоровления возвращают ее обратно.
Ученые объясняли подобные случаи исцеления эффектом плацебо, священники считали, что главную роль играют молитвы. Однако, когда в 2018 г. исследователи изучили образец земли с могилы, они нашли в нем штаммы стрептомицетов, продуцирующих вещества, способные подавлять рост нескольких опасных антибиотикоустойчивых бактерий.
Сегодня исследователи анализируют образцы из самых разных мест планеты: от пустыни Гоби до Тибетского плато. И одной почвой дело не ограничивается. К примеру, сотрудники Университета Восточной Англии выделили штаммы стрептомицинов с антимикробной активностью из... африканских муравьев! Эти муравьи выращивают для еды грибы, которые защищают от нападения патогенных бактерий с помощью других бактерий — продуцентов антибиотиков. Некоторые из этих антибиотиков проявляют активность в отношении инфекционных грибов, которые поражают человека и крайне трудно поддаются терапии существующими лекарствами.
Сейчас изучаются и другие бактерии, ассоциированные с живыми организмами, в первую очередь с насекомыми и рептилиями — с теми, кому приходится выживать в среде, «богатой» инфекционными агентами.

Медведица Маша, из слюны которой были выделены бактерии Bacillus pumilus (слева), продуцирующие антибиотик. Фото автора. Public Domain/CDC/ Dr. W. A. Clark
А ученые из московского Института биоорганической химии им. академиков М. М. Шемякина и Ю. А. Овчинникова РАН предположили, что бактерии, продуцирующие антимикробные вещества, можно найти в слюне животных, употребляющих в пищу несвежие животные продукты. Примером могут служить медведи, которые едят падаль и при этом не болеют. Применив оригинальный метод разделения бактерий, ученые действительно выделили из слюны сибирского бурого медведя штамм, производящий мощный антибиотик (Terekhov, Smirnov, Malakhova, 2018).
Продуценты антибиотиков можно найти не только «под носом», но и буквально в носу! К примеру, было известно, что условно-патогенный золотистый стафилококк, вызывающий болезнь только у людей с ослабленным иммунитетом, обнаруживается в носовой полости лишь у 30 % населения. Оказалось, что в носу «счастливцев», не подверженных заболеванию, часто присутствует другая бактерия — Staphylococcus lugdunensis, продуцирующая антибиотик лугдунин.
Анализ мазков госпитальных пациентов показал, что золотистый стафилококк встречается лишь у 6 % обладателей этой защитной бактерии и у 35 % тех, кто ее не имел. Лугдунин оказался эффективен также в отношении других бактериальных штаммов, устойчивых к широко применяемым антибиотикам.
Внимание исследователей до сих пор было сконцентрировано на суше, однако 70 % поверхности планеты покрыто водой, и морские микроорганизмы по меньшей мере так же интересны, как и почвенные микробы. А в последнее время взоры обращены на такие слабо изученные территории, как Арктика, для исследования которых создаются специальные проекты и программы.
В частности, команда норвежского проекта MabCent, которая с 2007 г. занимается изучением морских организмов в арктических водах, уже собрала образцы из более тысячи мест вблизи побережья Норвегии. Широко известен и международный проект PharmaSea, в котором участвуют 24 страны. Его задача — сбор биологических образцов из экстремальных мест обитания — самых горячих, самых глубоких и самых холодных частей планеты, чтобы найти средства лечения инфекционных болезней и заболеваний центральной нервной системы.

iChip — многоканальное устройство для выделения и выращивания «некультивируемых» бактерий в их естественной среде — состоит из пластин-чипов с 96 отверстиями (миниатюрные диффузионные камеры) и покрыт двумя полупроницаемыми мембранами, обеспечивающими диффузию питательных веществ и метаболитов. По: (Pandey, 2015). Вверху — пластина iChip. © CC BY-NC-SA 4.0/Science Museum Group Collections
В этом смысле в нашей стране с ее огромным природным разнообразием есть где развернуться. Особенно если учесть, что большая часть территории, в том числе с уникальными природными условиями, практически не изучена микробиологами.
Многие специалисты сегодня задаются вопросом: существует ли реальный шанс найти новые антибиотики с помощью массовых экспериментов? Ведь такие поиски велись десятилетиями, не исчерпаны ли ресурсы?
Перспективы, безусловно, есть, ведь до сих пор было собрано лишь то, что легко доступно и можно обнаружить с помощью довольно примитивных исследовательских методов. Арсенал же современных технологий позволяет значительно расширить спектр микроорганизмов, доступных для изучения.
Кроме того, искатели прошлого могли найти лишь те бактерии, которые можно легко культивировать в лаборатории на обычных питательных средах. А таких среди почвенных бактерий не более 1 %! Сегодня достигнут большой прогресс в изучении «некультивируемых» бактерий, которые перешли в разряд «трудно культивируемых».
Для работы с ними были разработаны специальные методы. Например, революционная технология iChip (изолирующий чип) позволяет выращивать бактерии в естественных для них условиях. Устройство представляет собой набор пластиковых пластин со множеством отверстий («одиночные камеры» для бактериальных клеток), окруженных полупроницаемыми мембранами, через которые проходят питательные вещества и метаболиты. С помощью этого подхода уже удалось выделить много новых природных микроорганизмов, в том числе бактерий, производящих уже упомянутый теиксобактин, эффективный против ряда лекарственно-устойчивых штаммов.
Совершенно новые возможности для «охотников за бактериями» открывает поиск не самих микроорганизмов, а генетических последовательностей, которые кодируют потенциальные антибиотики. Этот подход, основанный на исследовании общей ДНК всего образца, уже привел к определенным успехам. Так, при анализе более 2 тыс. образцов, собранных волонтерами в США, ученые из Рокфеллеровского университета обнаружили гены, кодирующие представителей нового класса антибиотиков — малацидинов. В лабораторных экспериментах эти антибиотики оказались эффективны против золотистого стафилококка, устойчивого к антибиотикам из класса пенициллинов (Hover, Kim, Katz et al., 2018).
Читатели, которые дочитали эту статью до конца, не хотите ли вы присоединиться к команде искателей антибиотиков? У вас есть уникальная возможность помочь найти решение важнейшей проблемы XXI в.! Регистрируйтесь на сайте проекта гражданской науки «Всероссийский атлас почвенных микроорганизмов как основа для поиска новых противомикробных продуцентов и ферментов с уникальными свойствами» (https://microbeatlas.ru), получайте инструкцию и ищите!
Литература
Власов В. В. Гражданская наука: приглашаются все! // НАУКА из первых рук. 2021. № 5/6(92). С. 128–145.
Седых С. Е., Воронина Е. Н., Галямова М. Р. и др. Наука в руках школьника: сибирские «охотники за микробами» // НАУКА из первых рук. 2021. № 5/6(92). С. 152–161.
Axenov-Gibanov D. V., Voytsekhovskaya I. V., Tokovenko B. T. Actinobacteria Isolated from an Underground Lake and Moonmilk Speleothem from the Biggest Conglomeratic Karstic Cave in Siberia as Sources of Novel Biologically Active Compounds // PLoS One. 2016. V. 11(2). P. e0149216.
Terekhov S. S., Smirnov I. V., Malakhova M. V. et al. Ultrahigh-throughput functional profiling of microbiota communities // Proc. Natl. Acad. Sci. USA. 2018. P. 9551–9556.
Terra L., Dyson P. J., Hitchings M. D. et al. A Novel Alkaliphilic Streptomyces Inhibits ESKAPE Pathogens // Frontiers Microbiol. 2018. URL: https://doi.org/10.3389/fmicb.2018.02458.
Qin Z., Munnoch J. T., Devine R. et al. Formicamycins, antibacterial polyketides produced by Streptomyces formicae isolated from African Tetraponera plant-ants // Chem. Sci. 2017. V. 8 (4). P. 3218–3227.
Британский профессор, будущий пэр и Нобелевский лауреат Александр Флеминг за работой в своей лаборатории в госпитале Святой Марии в Лондоне во время Второй мировой войны. Public Domain/Imperial War Museum